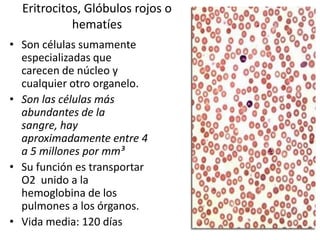
Eritrocitos, Glóbulos rojos o
hematíes
• Son células sumamente
especializadas que
carecen de núcleo y
cualquier otro organelo.
• Son las células más
abundantes de la
sangre, hay
aproximadamente entre 4
a 5 millones por mm³
• Su función es transportar
O2 unido a la
hemoglobina de los
pulmones a los órganos.
• Vida media: 120 días

El documento describe los componentes de la sangre y el sistema linfático. Explica que la sangre está compuesta de plasma, eritrocitos, leucocitos y plaquetas, y describe brevemente las funciones y características de cada uno. También cubre el sistema linfático, incluyendo los ganglios linfáticos, órganos linfoides y su organización y funcionalidad.